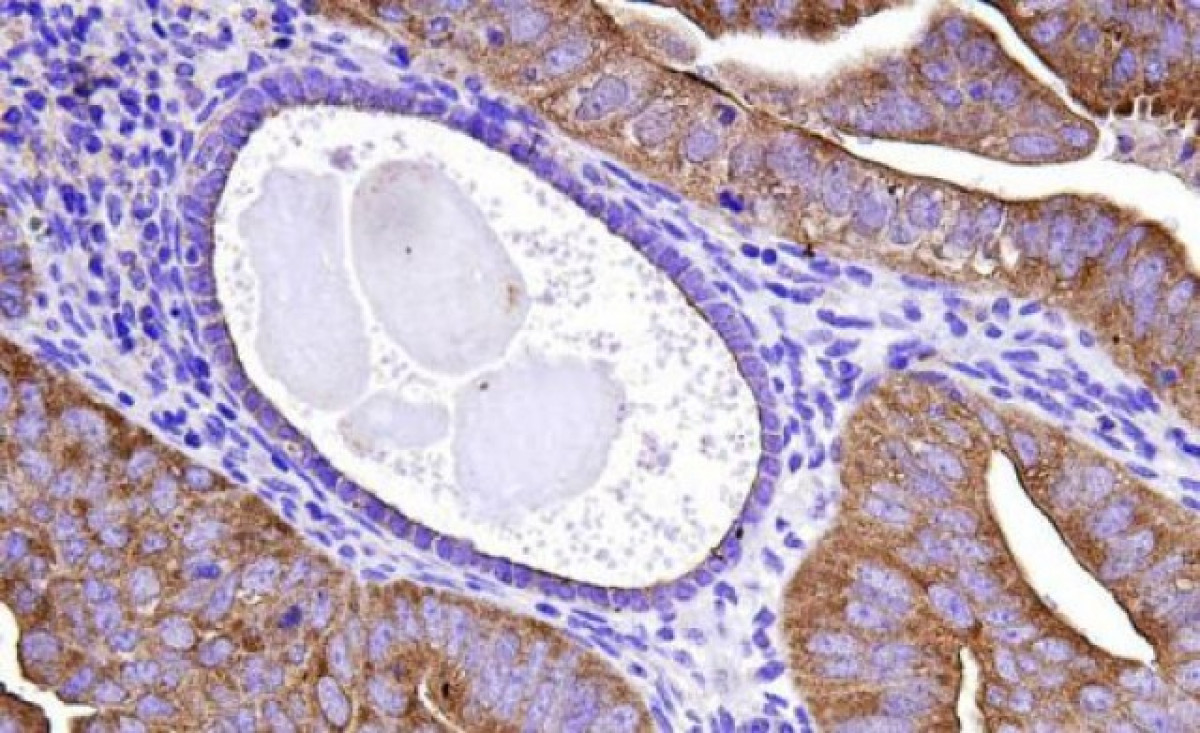

El càncer de pròstata pot aparèixer fins a 10 anys abans de diagnosticar-se
L'especialista en Urologia a la Consulta del Doctor Bucar, Santiago Bucar Terrades, ha alertat que el càncer de pròstata pot aparèixer fins a 10 anys abans de detectar-se.

L'especialista en Urologia a la Consulta del Doctor Bucar, Santiago Bucar Terrades, ha alertat que el càncer de pròstata pot aparèixer fins a 10 anys abans de detectar-se, pel que ha destacat la importància de diagnosticar-lo precoçment per augmentar les possibilitats de curació.
Es tracta del s egundo tumor maligne més freqüent en l' home , després del de pell. Els principals factors de risc són l'edat, especialment a partir dels 50 anys, i comptar amb familiars de primer grau que l'hagin patit abans dels 70 anys.
En aquest punt, l'expert ha explicat que l'elevada incidència no es deu a l'augment de la presència del tumor sinó que al fet que cada dia es diagnostiquen més casos en fases inicials de la malaltia.
"És en edats joves quan hi ha risc per a la supervivència i la qualitat de vida, i és només llavors quan podem aplicar tractaments curatius. Com que és un càncer de progressió lenta, hem de tenir en compte que aquest tumor diagnosticat als 70 anys (possiblement en un estat ja avançat), s'ha pogut iniciar fins i tot 10 anys abans, moment en el qual hagués estat plenament curable. Poques malalties malignes poden diagnosticar de forma precoç i, per tant, curar-se de manera tan senzilla i ràpida ", ha explicat el també membre de Saluspot.
Ara bé, aquest tumor no dóna símptomes, pel que ha advertit que si els pacients s'esperen a tenir símptomes urinaris per fer la prevenció, pot ser que no s'arribi "a temps" per diagnosticar-precoçment.
TRACTAMENTS PER AL CÀNCER DE PRÒSTATA
"Hi ha una tendència a infravalorar la importància de l'exploració (tacte rectal), per basar-se únicament en el PSA per al diagnòstic precoç del càncer de pròstata. Res més lluny de la realitat. És cert que la majoria de tumors malignes de la pròstata augmenten el PSA, però també és cert que un percentatge gens menyspreable no ho fa. Aquests tumors de pròstata que no augmenten el PSA solen ser més agressius. Cal reforçar l'actitud de fer sempre un tacte rectal si volem una correcta prevenció ", ha comentat .
Per tractar-lo, el doctor ha informat que actualment hi ha tres teràpies, dos per a la curació radical (cirurgia i radioteràpia) i una per a tractament pal·liatiu (tractament hormonal). En concret, la cirurgia es basa en l'extirpació de la totalitat de la glàndula prostàtica i pot realitzar-se mitjançant cirurgia oberta, laparoscòpica o robòtica.
"Avui dia, qualsevol de les tres tècniques són de correcta indicació, dependrà exclusivament de l'experiència del cirurgià l'aplicar una o altra. La radioteràpia pot aplicar-se de forma externa o implantant llavors radioactives directament en la pròstata en pacients que reuneixin unes característiques concretes (braquiteràpia) ", ha postil·lat.
Finalment, el doctor Bucar s'ha referit al tractament hormonal, una injecció intramuscular d'un fàrmac de forma trimestral o semestral. La tolerància a aquesta teràpia és "bona" i aconsegueix frenar la malaltia en la majoria de casos, encara que no es tracta d'una teràpia curativa, atès que el seu efecte no és indefinit. "En definitiva, el càncer de pròstata és una malaltia mortal i freqüent, però pot prevenir i curar si som conscients d'això", ha tancat.

Escriu el teu comentari